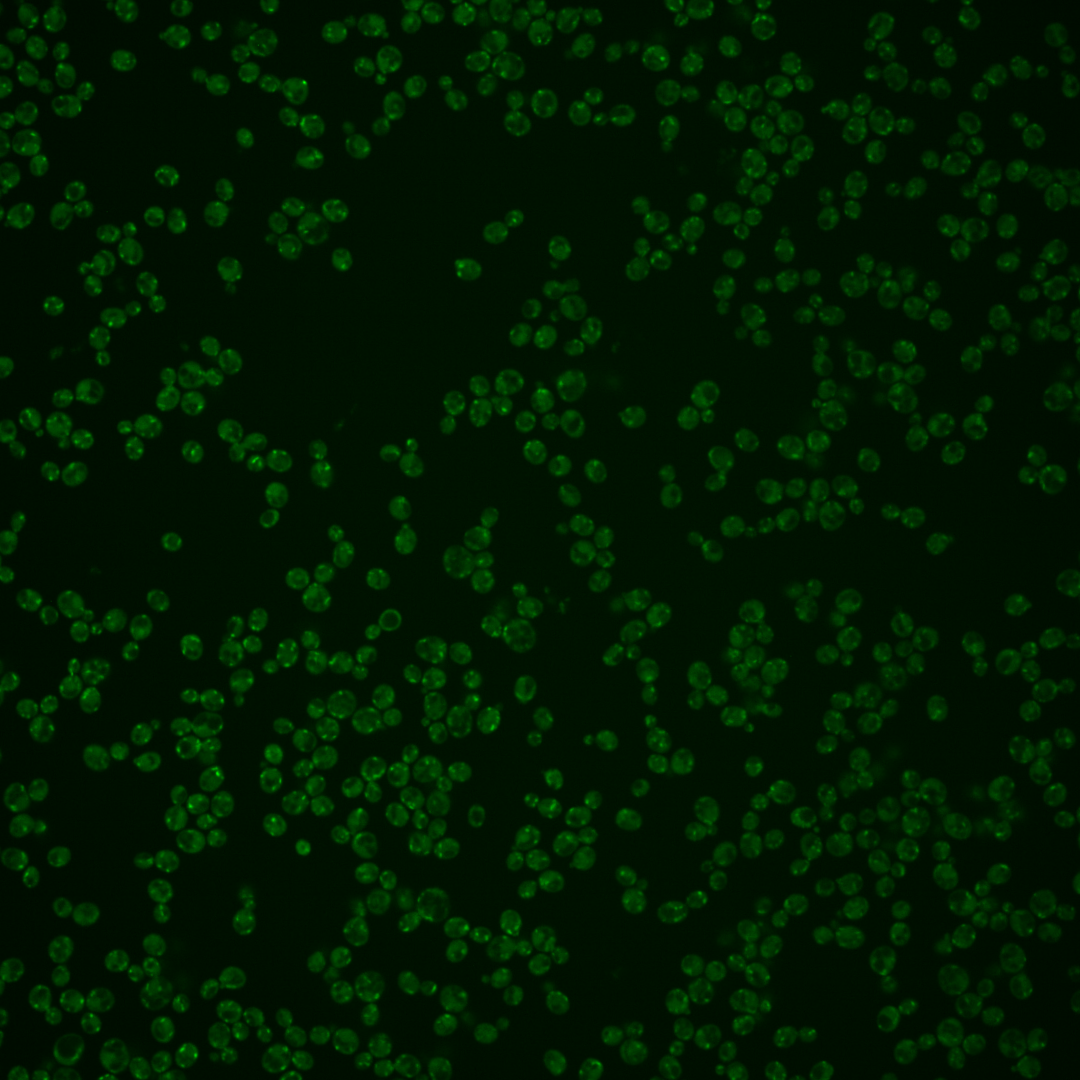
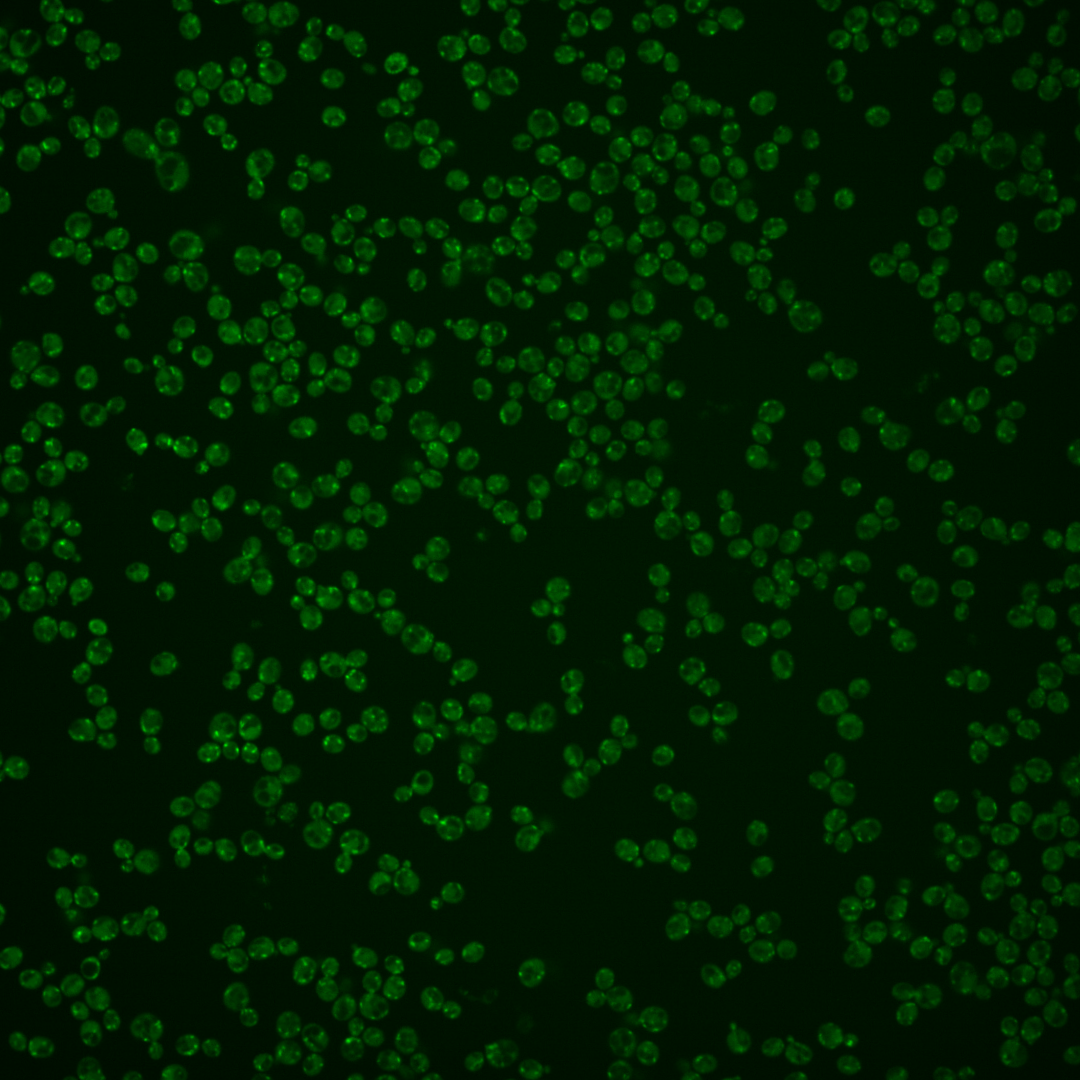
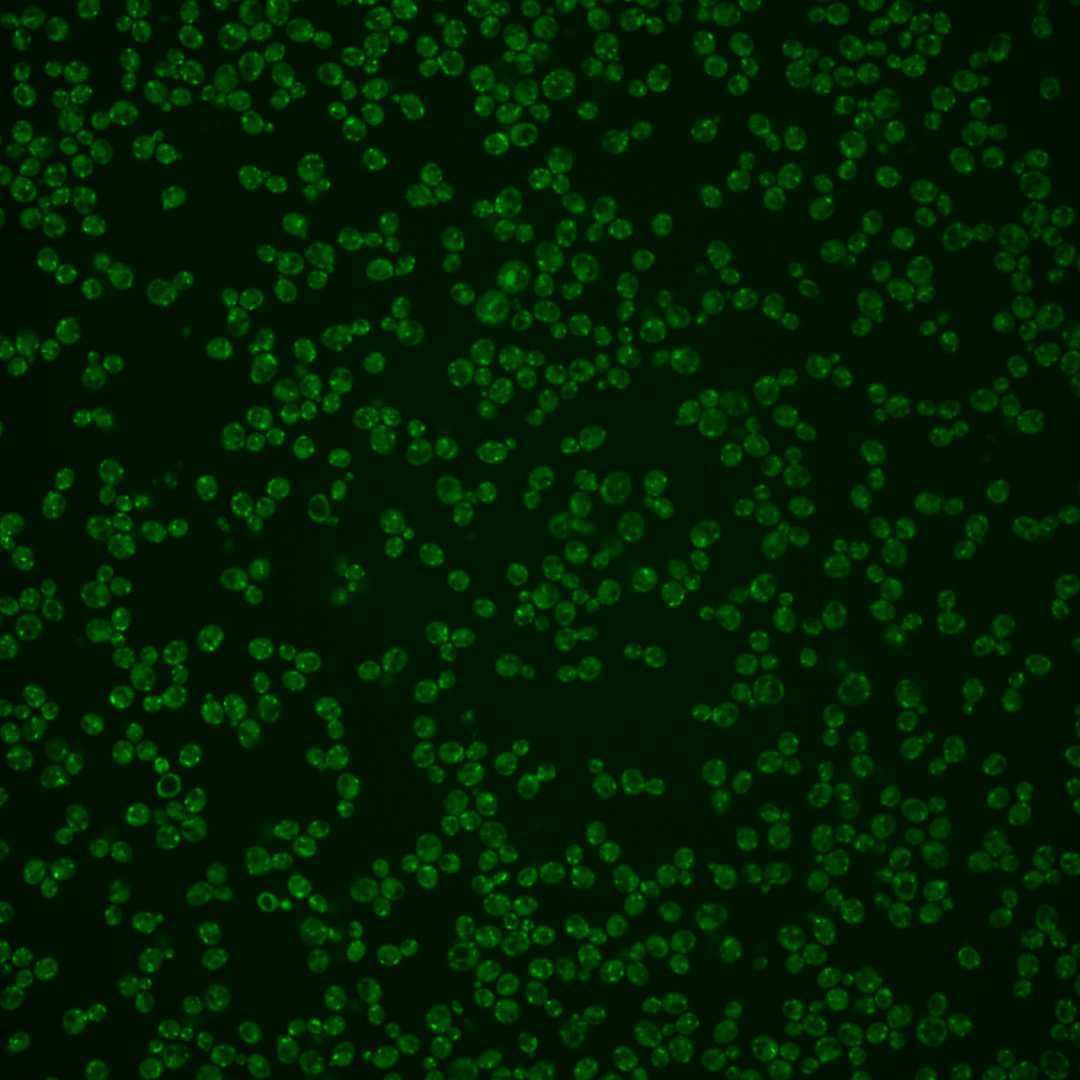
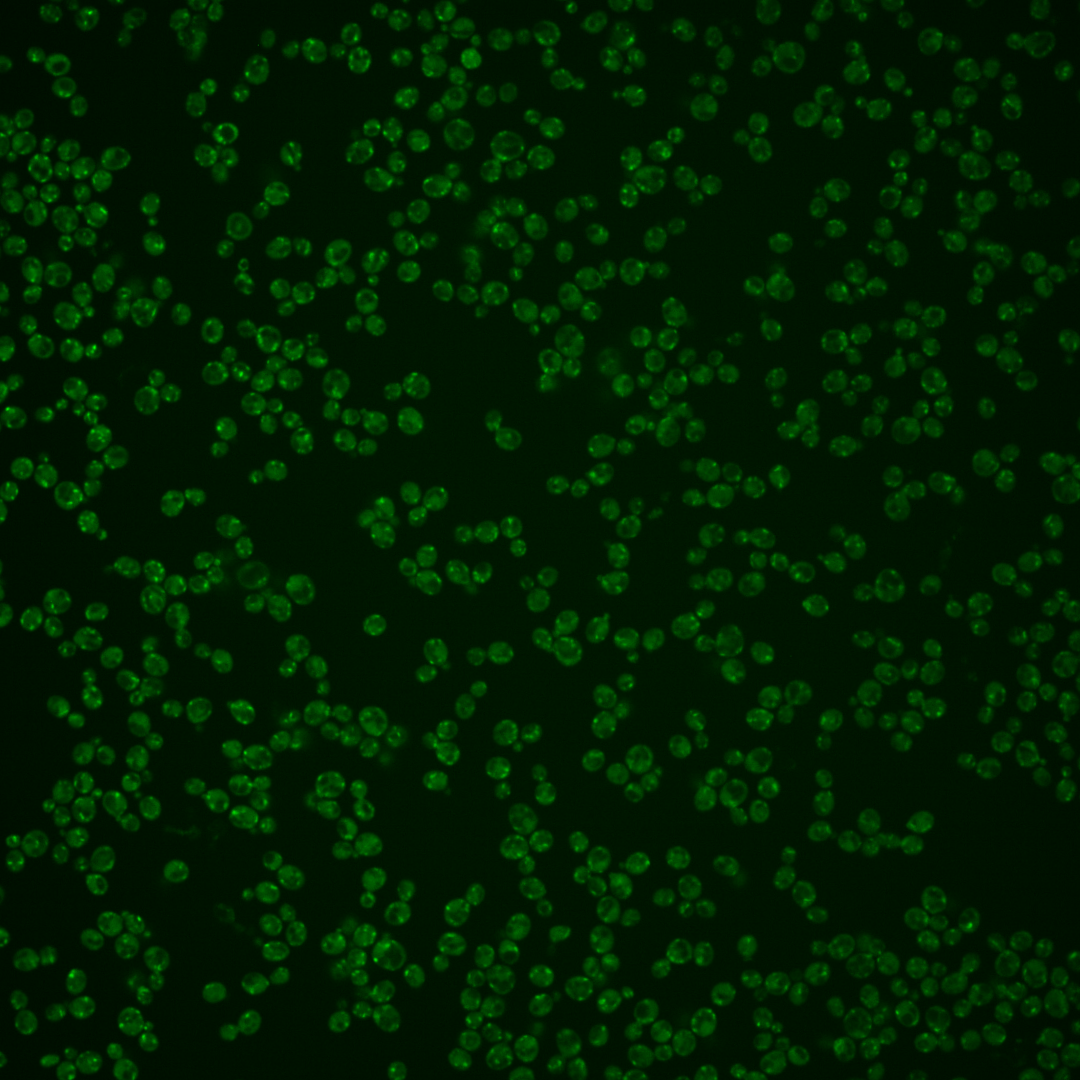
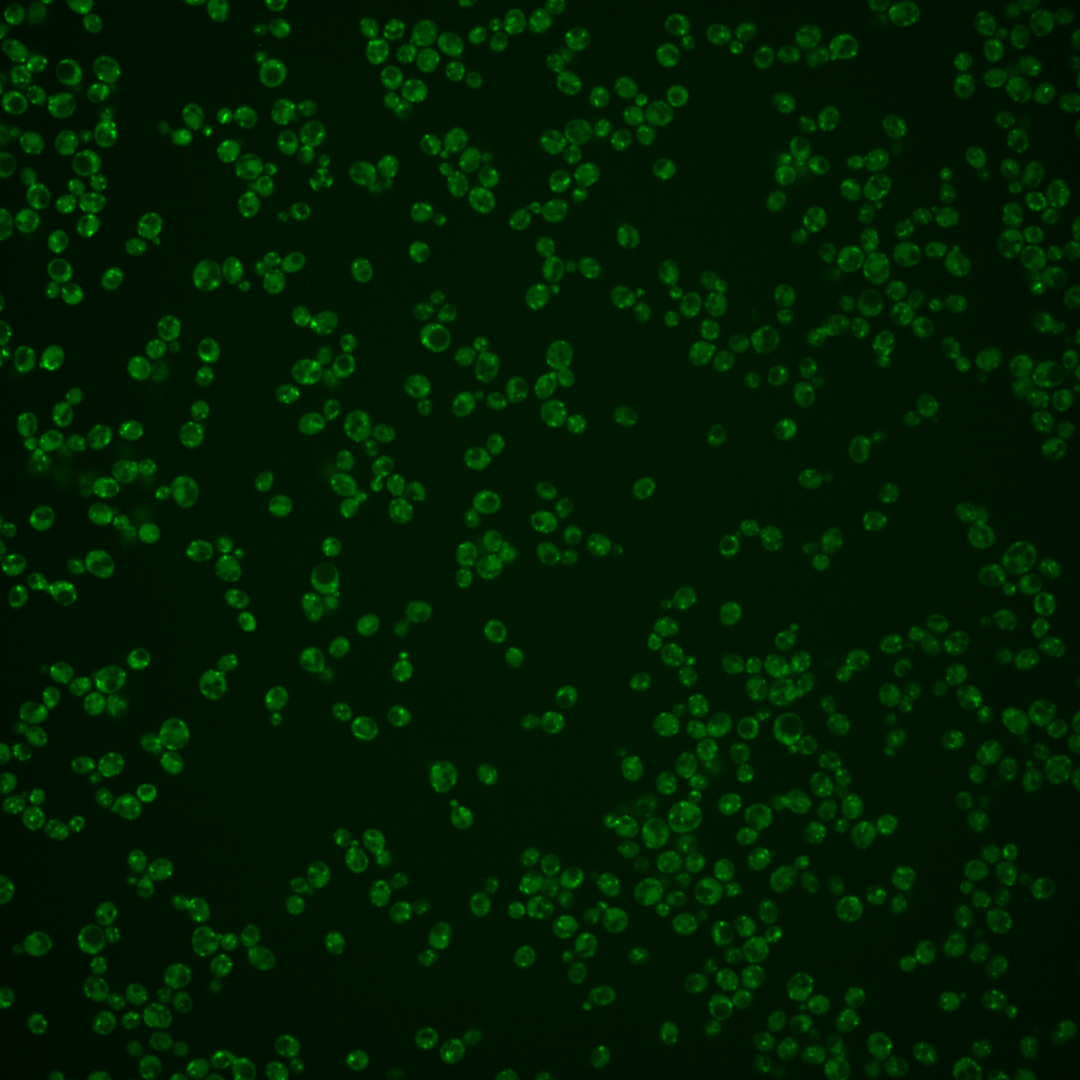
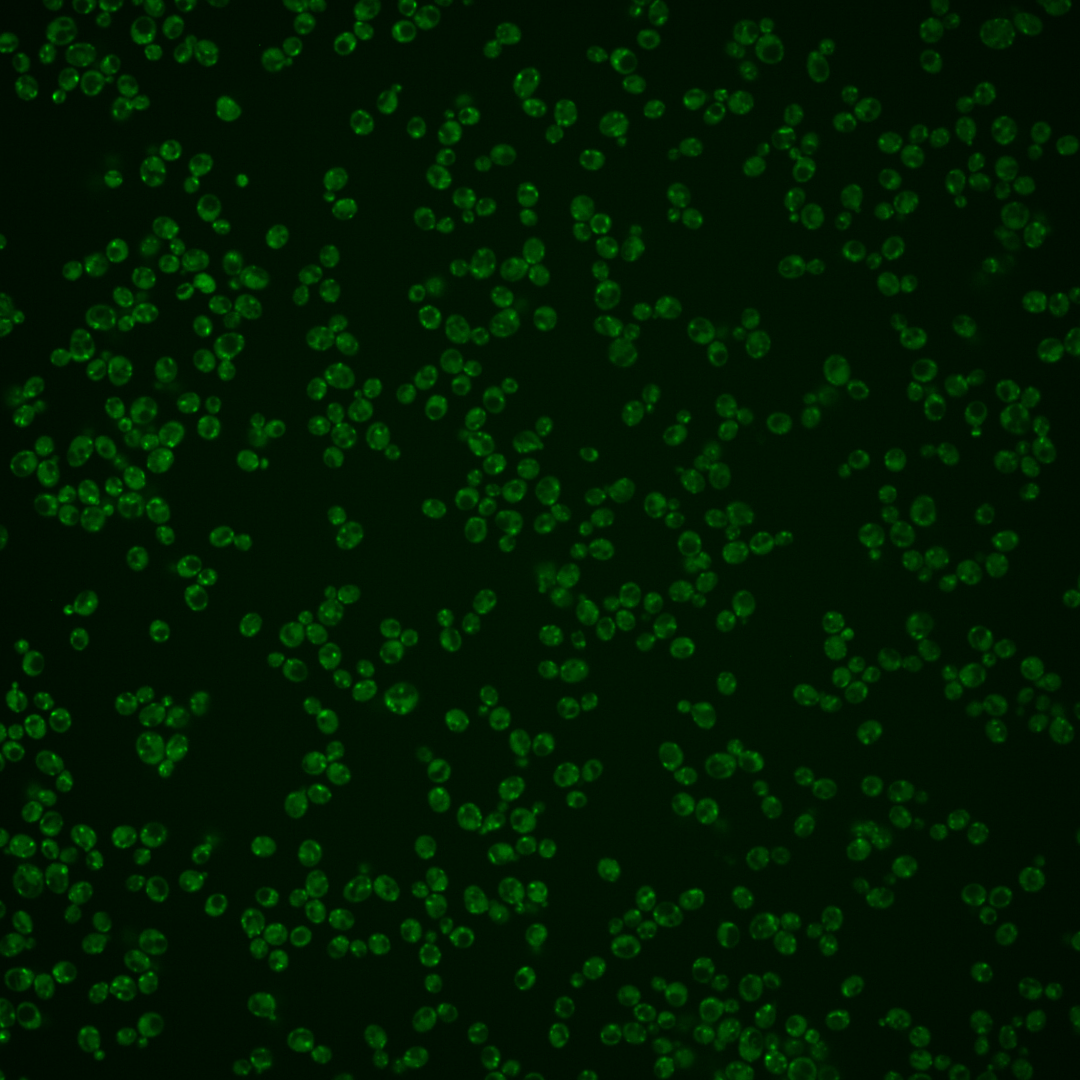

| Standard name | |
|---|---|
| Human Ortholog | |
| Description | Endosomal protein that interacts with phospholipid flippase Drs2p; interaction with Cdc50p is essential for Drs2p catalytic activity; mutations affect cell polarity and polarized growth; similar to Lem3p; CDC50 has a paralog, YNR048W, that arose from the whole genome duplication |
Micrographs




















































































Sub-cellular Localization
Yeast GFP Assignment
Protein Abundance
Localization Change
External localization resources
| ensLOC | DeepLoc | |||||||||||||||||||||||
|---|---|---|---|---|---|---|---|---|---|---|---|---|---|---|---|---|---|---|---|---|---|---|---|---|
| Localization | WT1 | WT2 | WT3 | RAP60 | RAP140 | RAP220 | RAP300 | RAP380 | RAP460 | RAP540 | RAP620 | RAP700 | HU80 | HU120 | HU160 | rpd3Δ_1 | rpd3Δ_2 | rpd3Δ_3 | WT1 | WT2 | WT3 | AF100 | AF140 | AF180 |
| Cortical Patches | 19 | 49 | 49 | 8 | 18 | 10 | 18 | 6 | 3 | 6 | 3 | 4 | 48 | 24 | 9 | 53 | 33 | 23 | 39 | 44 | 99 | 49 | 51 | 69 |
| Bud | 9 | 10 | 17 | 21 | 41 | 29 | 72 | 55 | 27 | 35 | 35 | 49 | 7 | 6 | 6 | 18 | 8 | 9 | 1 | 3 | 1 | 3 | 6 | 5 |
| Bud Neck | 0 | 0 | 0 | 0 | 0 | 0 | 0 | 0 | 0 | 0 | 0 | 0 | 0 | 0 | 0 | 0 | 0 | 0 | 0 | 0 | 1 | 1 | 0 | 1 |
| Bud Site | 0 | 0 | 1 | 1 | 2 | 13 | 14 | 11 | 10 | 23 | 10 | 11 | 0 | 0 | 0 | 0 | 1 | 1 | – | – | – | – | – | – |
| Cell Periphery | 1 | 1 | 5 | 3 | 1 | 2 | 8 | 6 | 3 | 2 | 1 | 9 | 2 | 2 | 1 | 5 | 3 | 5 | 0 | 0 | 0 | 0 | 0 | 0 |
| Cytoplasm | 9 | 15 | 9 | 17 | 15 | 14 | 13 | 12 | 8 | 4 | 5 | 5 | 18 | 23 | 27 | 32 | 34 | 30 | 1 | 0 | 0 | 4 | 2 | 4 |
| Endoplasmic Reticulum | 19 | 44 | 28 | 7 | 9 | 15 | 11 | 8 | 4 | 4 | 5 | 9 | 48 | 17 | 5 | 17 | 15 | 10 | 6 | 6 | 5 | 11 | 10 | 9 |
| Endosome | 16 | 10 | 51 | 40 | 63 | 10 | 11 | 54 | 15 | 9 | 1 | 18 | 61 | 57 | 115 | 92 | 80 | 74 | 67 | 43 | 70 | 61 | 50 | 65 |
| Golgi | 32 | 62 | 78 | 11 | 17 | 0 | 1 | 3 | 0 | 1 | 2 | 3 | 93 | 108 | 47 | 106 | 83 | 41 | 142 | 119 | 208 | 160 | 173 | 210 |
| Mitochondria | 203 | 115 | 228 | 246 | 323 | 440 | 613 | 534 | 377 | 344 | 351 | 394 | 50 | 30 | 81 | 40 | 37 | 23 | 18 | 13 | 23 | 50 | 46 | 30 |
| Nucleus | 0 | 0 | 0 | 0 | 2 | 1 | 4 | 2 | 3 | 1 | 1 | 3 | 1 | 1 | 0 | 8 | 6 | 2 | 0 | 0 | 1 | 0 | 0 | 2 |
| Nuclear Periphery | 2 | 0 | 1 | 1 | 0 | 4 | 4 | 6 | 5 | 2 | 5 | 4 | 1 | 0 | 0 | 3 | 1 | 2 | 1 | 0 | 1 | 2 | 1 | 1 |
| Nucleolus | 5 | 2 | 1 | 5 | 6 | 10 | 25 | 26 | 12 | 14 | 14 | 15 | 0 | 0 | 4 | 5 | 2 | 3 | 0 | 0 | 0 | 0 | 0 | 0 |
| Peroxisomes | 2 | 2 | 19 | 33 | 64 | 23 | 16 | 51 | 15 | 16 | 8 | 25 | 11 | 14 | 65 | 1 | 12 | 2 | 15 | 7 | 41 | 12 | 14 | 13 |
| SpindlePole | 4 | 1 | 12 | 12 | 8 | 5 | 20 | 29 | 13 | 15 | 5 | 7 | 14 | 24 | 8 | 32 | 28 | 37 | 3 | 2 | 2 | 2 | 3 | 1 |
| Vac/Vac Membrane | 6 | 3 | 4 | 5 | 8 | 2 | 3 | 18 | 10 | 7 | 5 | 13 | 12 | 17 | 27 | 25 | 20 | 12 | 7 | 10 | 3 | 16 | 12 | 10 |
| Unique Cell Count | 256 | 204 | 365 | 315 | 419 | 478 | 662 | 640 | 408 | 380 | 365 | 438 | 267 | 257 | 299 | 350 | 285 | 217 | 306 | 255 | 465 | 383 | 379 | 429 |
| Labelled Cell Count | 327 | 314 | 503 | 410 | 577 | 578 | 833 | 821 | 505 | 483 | 451 | 569 | 366 | 323 | 395 | 437 | 363 | 274 | 306 | 255 | 465 | 383 | 379 | 429 |
Yeast GFP Assignment
Protein Abundance
| Screen | WT1 | WT2 | WT3 | RAP60 | RAP140 | RAP220 | RAP300 | RAP380 | RAP460 | RAP540 | RAP620 | RAP700 | HU80 | HU120 | HU160 | rpd3Δ_1 | rpd3Δ_2 | rpd3Δ_3 | AF100 | AF140 | AF180 |
|---|---|---|---|---|---|---|---|---|---|---|---|---|---|---|---|---|---|---|---|---|---|
| Mean Cell GFP Intensity (1e-4) | 7.2 | 8.6 | 7.4 | 6.9 | 6.7 | 5.9 | 5.7 | 5.8 | 5.5 | 5.4 | 5.0 | 5.6 | 9.1 | 9.0 | 8.5 | 8.7 | 8.4 | 7.7 | 9.1 | 9.3 | 9.8 |
| Std Deviation (1e-4) | 1.0 | 1.6 | 1.0 | 1.5 | 1.4 | 1.3 | 1.4 | 1.3 | 1.7 | 1.1 | 1.4 | 3.6 | 1.5 | 1.4 | 1.5 | 1.7 | 1.7 | 1.5 | 1.5 | 1.5 | 1.6 |
| Intensity Change (Log2) | – | – | – | -0.1 | -0.14 | -0.32 | -0.38 | -0.35 | -0.43 | -0.45 | -0.55 | -0.39 | 0.3 | 0.28 | 0.2 | 0.24 | 0.19 | 0.06 | 0.3 | 0.33 | 0.4 |
Localization Change
| Localization | RAP60 | RAP140 | RAP220 | RAP300 | RAP380 | RAP460 | RAP540 | RAP620 | RAP700 | HU80 | HU120 | HU160 | rpd3Δ_1 | rpd3Δ_2 | rpd3Δ_3 |
|---|---|---|---|---|---|---|---|---|---|---|---|---|---|---|---|
| Cortical Patches | -5.1 | -4.6 | -6.4 | -6.6 | -8.4 | -7.0 | -6.2 | -6.6 | -7.1 | 1.6 | -1.6 | -4.7 | 0.7 | -0.7 | -1.0 |
| Bud | 1.1 | 2.7 | 0.9 | 3.4 | 2.3 | 1.2 | 2.4 | 2.6 | 3.4 | -1.3 | -1.5 | -1.9 | 0.3 | -1.2 | -0.3 |
| Bud Neck | 0 | 0 | 0 | 0 | 0 | 0 | 0 | 0 | 0 | 0 | 0 | 0 | 0 | 0 | 0 |
| Bud Site | 0 | 0 | 2.8 | 2.4 | 0 | 2.6 | 4.5 | 2.7 | 2.6 | 0 | 0 | 0 | 0 | 0 | 0 |
| Cell Periphery | 0 | 0 | 0 | 0 | 0 | 0 | 0 | 0 | 0.7 | 0 | 0 | 0 | 0 | 0 | 0 |
| Cytoplasm | 2.0 | 0.9 | 0.4 | -0.5 | -0.6 | -0.5 | -1.5 | -1.1 | -1.4 | 2.6 | 3.6 | 3.7 | 3.8 | 4.8 | 5.3 |
| Endoplasmic Reticulum | -3.2 | -3.6 | -3.0 | -4.8 | -5.3 | -4.7 | -4.5 | -4.1 | -3.8 | 3.9 | -0.5 | -3.5 | -1.5 | -1.2 | -1.4 |
| Endosome | -0.5 | 0.4 | -6.6 | -7.9 | -2.8 | -5.1 | -5.8 | -7.2 | -5.0 | 2.9 | 2.7 | 7.3 | 4.1 | 4.4 | 5.7 |
| Golgi | -6.9 | -7.4 | -10.6 | -12.2 | -11.7 | -9.8 | -9.4 | -9.0 | -9.7 | 3.8 | 5.5 | -1.9 | 2.7 | 2.3 | -0.7 |
| Mitochondria | 4.4 | 4.5 | 10.5 | 12.0 | 7.5 | 10.1 | 9.1 | 11.2 | 9.3 | -10.9 | -12.7 | -9.1 | -14.1 | -12.7 | -12.2 |
| Nucleus | 0 | 0 | 0 | 0 | 0 | 0 | 0 | 0 | 0 | 0 | 0 | 0 | 0 | 0 | 0 |
| Nuclear Periphery | 0 | 0 | 0 | 0 | 0 | 0 | 0 | 0 | 0 | 0 | 0 | 0 | 0 | 0 | 0 |
| Nucleolus | 0 | 0 | 0 | 3.4 | 3.6 | 2.9 | 3.3 | 3.4 | 3.2 | 0 | 0 | 0 | 0 | 0 | 0 |
| Peroxisomes | 2.6 | 4.6 | -0.3 | -2.4 | 1.7 | -1.0 | -0.6 | -2.2 | 0.3 | -0.6 | 0.1 | 6.4 | -4.0 | -0.6 | -2.7 |
| SpindlePole | 0.4 | -1.2 | -2.3 | -0.2 | 1.0 | -0.1 | 0.5 | -1.7 | -1.6 | 1.2 | 3.2 | -0.5 | 3.3 | 3.4 | 5.8 |
| Vacuole | 0 | 0.9 | 0 | 0 | 1.8 | 1.4 | 0.8 | 0 | 1.8 | 2.7 | 3.8 | 4.8 | 4.1 | 4.0 | 3.2 |
External localization resources
Images






























Protein Concentration and Protein Localization Data
| R1 | R2 | R3 | ||||||||||||||||
|---|---|---|---|---|---|---|---|---|---|---|---|---|---|---|---|---|---|---|
| G1 Pre-START | G1 Post-START | S/G2 | Metaphase | Anaphase | Telophase | G1 Pre-START | G1 Post-START | S/G2 | Metaphase | Anaphase | Telophase | G1 Pre-START | G1 Post-START | S/G2 | Metaphase | Anaphase | Telophase | |
| Concentration | 5.4989 | 6.0248 | 5.6896 | 5.7449 | 5.7999 | 5.5542 | 4.2853 | 4.7723 | 4.9515 | 3.8722 | 5.1615 | 4.4907 | 3.8865 | 4.1162 | 3.673 | 3.6944 | 3.3587 | 3.8478 |
| Actin | 0.0473 | 0.0441 | 0.0198 | 0.0015 | 0.0505 | 0.0343 | 0.0583 | 0.0101 | 0.0201 | 0.0323 | 0.0417 | 0.0316 | 0.0301 | 0.0375 | 0.0161 | 0.0209 | 0.0049 | 0.0191 |
| Bud | 0.0005 | 0.001 | 0.0035 | 0.0001 | 0.0012 | 0.0009 | 0.0008 | 0.0007 | 0.0016 | 0.0014 | 0.0023 | 0.0005 | 0.0006 | 0.0003 | 0.0005 | 0.0004 | 0.0004 | 0.0005 |
| Bud Neck | 0.0007 | 0.0005 | 0.0005 | 0.0002 | 0.0005 | 0.0011 | 0.0033 | 0.0007 | 0.0024 | 0.0015 | 0.0025 | 0.0023 | 0.0011 | 0.0004 | 0.0005 | 0.0373 | 0.0004 | 0.0013 |
| Bud Periphery | 0.0004 | 0.0008 | 0.0013 | 0.0001 | 0.0014 | 0.0005 | 0.0008 | 0.0004 | 0.0012 | 0.002 | 0.0034 | 0.0008 | 0.0009 | 0.0002 | 0.0004 | 0.0004 | 0.0003 | 0.0003 |
| Bud Site | 0.0017 | 0.0032 | 0.0014 | 0.0002 | 0.0016 | 0.0007 | 0.0078 | 0.0039 | 0.0061 | 0.0027 | 0.005 | 0.001 | 0.0043 | 0.0008 | 0.0007 | 0.0024 | 0.0006 | 0.0005 |
| Cell Periphery | 0.0001 | 0.0001 | 0.0001 | 0 | 0.0001 | 0.0001 | 0.0003 | 0.0001 | 0.0002 | 0.0003 | 0.0004 | 0.0003 | 0.0004 | 0.0001 | 0.0001 | 0.0001 | 0.0001 | 0.0001 |
| Cytoplasm | 0.0037 | 0.0078 | 0.005 | 0.0015 | 0.0021 | 0.0048 | 0.0102 | 0.011 | 0.0082 | 0.0082 | 0.004 | 0.0075 | 0.0059 | 0.0116 | 0.0033 | 0.0026 | 0.0042 | 0.0122 |
| Cytoplasmic Foci | 0.1669 | 0.1853 | 0.1587 | 0.1652 | 0.1398 | 0.1329 | 0.1265 | 0.1641 | 0.1209 | 0.1302 | 0.0937 | 0.1003 | 0.1522 | 0.1716 | 0.1238 | 0.1429 | 0.1262 | 0.1128 |
| Eisosomes | 0.0002 | 0.0001 | 0.0001 | 0 | 0.0001 | 0.0001 | 0.0004 | 0 | 0.0001 | 0.0001 | 0.0008 | 0.0001 | 0.0002 | 0.0003 | 0.0001 | 0.0002 | 0 | 0.0001 |
| Endoplasmic Reticulum | 0.0006 | 0.0062 | 0.0005 | 0.0002 | 0.0007 | 0.0005 | 0.0058 | 0.0013 | 0.0035 | 0.002 | 0.0057 | 0.0042 | 0.0069 | 0.0009 | 0.0013 | 0.0008 | 0.002 | 0.0012 |
| Endosome | 0.2038 | 0.2493 | 0.2047 | 0.2029 | 0.1954 | 0.168 | 0.3138 | 0.3342 | 0.2884 | 0.3059 | 0.3047 | 0.2623 | 0.2549 | 0.3277 | 0.2641 | 0.2955 | 0.3247 | 0.2057 |
| Golgi | 0.455 | 0.4141 | 0.5046 | 0.5322 | 0.4421 | 0.517 | 0.3279 | 0.4221 | 0.4818 | 0.4288 | 0.4336 | 0.5015 | 0.4144 | 0.4184 | 0.4965 | 0.3926 | 0.477 | 0.5734 |
| Lipid Particles | 0.0256 | 0.0088 | 0.0095 | 0.0078 | 0.0387 | 0.021 | 0.0556 | 0.0147 | 0.009 | 0.0242 | 0.0399 | 0.0169 | 0.028 | 0.0047 | 0.0141 | 0.0662 | 0.0175 | 0.0175 |
| Mitochondria | 0.0231 | 0.0247 | 0.0269 | 0.0393 | 0.014 | 0.0418 | 0.0184 | 0.0113 | 0.0201 | 0.0151 | 0.0182 | 0.037 | 0.0333 | 0.0098 | 0.0348 | 0.0094 | 0.0091 | 0.0276 |
| None | 0.0034 | 0.0002 | 0.004 | 0.0001 | 0.0003 | 0.0022 | 0.004 | 0.0002 | 0.0011 | 0.0044 | 0.0015 | 0.0008 | 0.0045 | 0.0003 | 0.0002 | 0.0003 | 0.0015 | 0.0009 |
| Nuclear Periphery | 0.0001 | 0.0005 | 0.0002 | 0 | 0.0002 | 0.0001 | 0.016 | 0.0008 | 0.0024 | 0.0019 | 0.0215 | 0.0045 | 0.0089 | 0.0007 | 0.0004 | 0.0006 | 0.0012 | 0.0015 |
| Nucleolus | 0.0004 | 0.0006 | 0.0006 | 0 | 0.0001 | 0.0003 | 0.0004 | 0.0001 | 0.0002 | 0.002 | 0.0012 | 0.0004 | 0.0017 | 0.0001 | 0.0004 | 0.0001 | 0.0001 | 0.0001 |
| Nucleus | 0.0002 | 0.0001 | 0.0009 | 0 | 0.0001 | 0.0006 | 0.0072 | 0.0006 | 0.001 | 0.0032 | 0.0025 | 0.0009 | 0.0014 | 0.0001 | 0.0001 | 0.0001 | 0.0002 | 0.0003 |
| Peroxisomes | 0.0625 | 0.0496 | 0.0543 | 0.0473 | 0.1079 | 0.0696 | 0.0312 | 0.0168 | 0.0252 | 0.0224 | 0.005 | 0.0177 | 0.038 | 0.0099 | 0.037 | 0.0226 | 0.023 | 0.0211 |
| Punctate Nuclear | 0.0008 | 0.0002 | 0.001 | 0.0001 | 0.0007 | 0.0013 | 0.0036 | 0.0005 | 0.001 | 0.0061 | 0.0044 | 0.0013 | 0.0053 | 0.0006 | 0.0004 | 0.0008 | 0.001 | 0.0008 |
| Vacuole | 0.002 | 0.0015 | 0.0013 | 0.0006 | 0.0012 | 0.001 | 0.0047 | 0.0043 | 0.0032 | 0.0035 | 0.0035 | 0.0044 | 0.0046 | 0.0024 | 0.0031 | 0.0021 | 0.0035 | 0.0013 |
| Vacuole Periphery | 0.0009 | 0.0013 | 0.001 | 0.0007 | 0.0014 | 0.0011 | 0.0031 | 0.0018 | 0.0024 | 0.002 | 0.0044 | 0.0037 | 0.0024 | 0.0016 | 0.0022 | 0.0016 | 0.0022 | 0.0015 |
Sequencing Data
| R1 | R2 | |||||||||
|---|---|---|---|---|---|---|---|---|---|---|
| G1 Post-START | S/G2 | Metaphase | Anaphase | Telophase | G1 Post-START | S/G2 | Metaphase | Anaphase | Telophase | |
| Gene Expression | 31.432 | 36.0665 | 21.1613 | 28.0282 | 26.1549 | 22.506 | 31.5904 | 30.6227 | 31.5214 | 35.0678 |
| Translational Efficiency | 1.023 | 0.744 | 1.1557 | 0.6456 | 0.9275 | 1.3639 | 0.9215 | 0.7537 | 0.7455 | 0.9677 |
Hit Data
| Dataset | Hit |
|---|---|
| Protein Concentration | ✘ |
| Protein Localization | ✘ |
| Gene Expression | ✘ |
| Translational Efficiency | ✘ |
Endocytosis
| Temp | Actin Patch (Sac6-tdTomato) | Cortical Patch (Sla1-GFP) | Late Endosome (Snf7-GFP) | Vacuole (Vph1-GFP) |
|---|---|---|---|---|
| 37℃ | ||||
| RT |
Cell Cycle Omics
CYCLoPs (Cdc50-GFP)
| Gene / Allele | Actin Patch (Sac6-tdTomato) | Cortical Patch (Sla1-GFP) | Late Endosome (Snf7-GFP) | Vacuole (Sac6-tdTomato) |
|---|
| Gene | Images |
|---|
| Gene | Images |
|---|
Images are not yet available
Images are not yet available